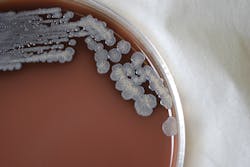
12278 611277bc80f41 12278 611277bc80f41

CDC issues statement on Melioidosis cases
The Centers for Disease Control and Prevention (CDC) has confirmed a new fatal case of the rare disease melioidosis in Georgia that is linked to three previous cases in different states. The cases have included adults and children. Two of the four patients had no known risk factors for melioidosis; two died.
Whole genome sequencing at CDC shows the bacterial strains that sickened the patients – one each in Georgia, Kansas, Texas and Minnesota – closely match each other, suggesting there is a common source for these cases. They appear most closely related to strains found in Asia, particularly South Asia, even though none of the patients had traveled internationally.
CDC has collected and tested more than 100 samples from products, soil and water in and around the patients’ homes. No samples have yet been positive for the bacteria Burkholderia pseudomallei, which causes melioidosis.
Currently, CDC believes the most likely cause is an imported product (such as a food or drink, personal care, cleaning products or medicine) or an ingredient in one of those types of products. The bacteria normally lives in moist soil and water. However, in rare cases, it has also been found to contaminate wet or moist products in the areas where the bacteria are common.
Identifying a single source of infection may be difficult because:
- The patients are spread apart by geography and time their illness began.
- Each could have been exposed to potentially hundreds of products before they became ill.
- Unlike the germs that cause most foodborne outbreaks, the bacteria responsible for melioidosis can take two to three weeks to make someone sick. This expands the window of time that investigators need to explore and means people may be less likely to remember everything they were exposed to before becoming ill.
CDC is asking clinicians to watch for any acute bacterial infection that doesn’t respond to normal antibiotics and consider melioidosis – regardless of whether the patient traveled outside the United States. CDC also urges clinicians not to rule out melioidosis as a possible diagnosis in children and those who were previously healthy and without known risk factors for melioidosis.
Although healthy people may get melioidosis, underlying medical conditions may increase the risk of disease. The major risk factors are diabetes, liver or kidney disease, chronic lung disease, cancer or another condition that weakens the immune system. Most children who get melioidosis do not have risk factors. People experiencing cough, chest pain, high fever, headache or unexplained weight loss should see their doctor.